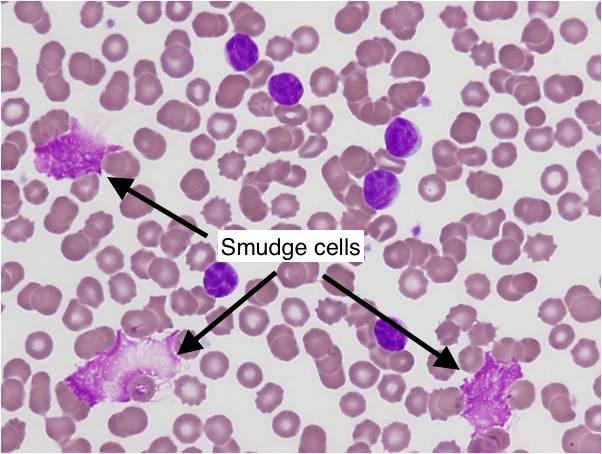

| Leukemia | Demo | Key Finding / Buzzword | High-Yield Assoc. / Comp. | 1st Line Tx |
|---|---|---|---|---|
| ALL | Kids | Lymphoblasts, TdT+ | CNS involvement, Down Syn. (>5yo) | Chemo + IT prophylaxis |
| AML | Adults (~65) | Myeloblasts, Auer rods, MPO+ | DIC (w/ APL t(15;17)) | Chemo; ATRA for APL |
| CLL | Elderly (>65) | Smudge cells, incidental lymphocytosis | Richter’s transformation, AIHA | Watch & wait (if asymp.) |
| CML | Adults (~50) | t(9;22) Philadelphia Chr. (BCR-ABL), ↓ LAP | Blast crisis | TKI (Imatinib) |

Mnemonic
In timeline, ALL and CLL are on lateral, and CML and AML are on middle.
Mnemonic
A mnemonic for acute leukemia ages:
- ALL - adults Least likely ~ children (10 yrs)
- AML - adults Most likely (50 yrs)
Another:
- AML= (A)uer rods and (M)yeloperoxidase positive
Tip
Characteristic of CLL would be the “smudge cells”
Epidemiology
- Acute lymphoblastic leukemia
- Peak incidence: 2–5 years
- Most common malignant disease in children
- ∼ 80% of acute leukemias during childhood are lymphoblastic.
Etiology
Acute lymphoblastic leukemia (ALL)
- Genetic or chromosomal factors
- Down syndrome: Risk of ALL is, like that of AML, 10–20 times higher in patients with Down syndrome compared to the general population.
- Neurofibromatosis type 1
- Ataxia telangiectasia
Pathophysiology
Clinical features
- Oncologic emergencies can be the first sign of leukemia, e.g., an elderly patient presenting with priapism or DIC may have leukostasis (more common in AML than ALL)
Warning
The identification of DIC suggests APL, which is a medical emergency. Consult hematology and/or oncology immediately and transfer the patient to a critical care unit.
Diagnostics
- Acute Lymphoblastic Leukemia (ALL)
- Who: Primarily children.
- Smear: >20% Lymphoblasts.
- Markers: TdT+, MPO negative. B-ALL markers (CD10, CD19, CD20), T-ALL markers (CD2-CD8).
- Genetics: t(9;22) [Ph chromosome] indicates poor prognosis.
- Acute Myeloid Leukemia (AML)
- Who: Primarily older adults.
- Smear: >20% Myeloblasts; Auer rods are pathognomonic.
- Markers: MPO+. Myeloid markers (CD13, CD33).
- Genetics: t(15;17) is diagnostic for APL subtype; treat with ATRA.
- Chronic Lymphocytic Leukemia (CLL)
- Who: Elderly (>60 years).
- Smear: High count of mature lymphocytes; Smudge Cells are classic.
- Markers: Co-expression of CD5 and B-cell markers (CD19, CD20, CD23).
- Chronic Myeloid Leukemia (CML)
- Who: Adults (40-60 years).
- Labs: Very high WBC (>100k) with all stages of maturing granulocytes, ↑basophils. Low LAP score.
- Genetics: Philadelphia Chromosome t(9;22) creating the BCR-ABL1 fusion gene is diagnostic.
Tip
MPO and LAP
- MPO (Myeloperoxidase)
- Primary marker for identifying cells of myeloid lineage
- Can help distinguish Acute Myeloid Leukemia (AML) from Acute Lymphoblastic Leukemia (ALL):
- AML cells are typically MPO positive
- ALL cells are MPO negative
- LAP (Leukocyte Alkaline Phosphatase)
- Enzyme present in mature neutrophils
- LAP score helps differentiate between various myeloproliferative conditions:
- Elevated in infections, inflammatory conditions, and polycythemia vera
- Low or absent in Chronic Myeloid Leukemia (CML)
- CML: All neutrophils are clonal (BCR-ABL1+), dysfunctional, and LAP-negative due to stem-cell-level dominance.
- AML: Residual neutrophils are derived from non-clonal, normal stem cells that escape leukemic transformation, retaining LAP activity.
- Particularly valuable in distinguishing CML from leukemoid reaction:
- CML: Low LAP score
- Leukemoid reaction: High LAP score
| Leukemia Type | MPO | LAP |
|---|---|---|
| AML | Positive (+) | Normal to Increased |
| CML | Positive (+) But no Auer rods | Decreased (-) |
| ALL | Negative (-) | Normal to Increased |
| CLL | Negative (-) | Normal to Increased |

Tip
Some subtypes (especially M3, or APL) exhibit Auer rods
- Pink-red, rod-shaped granular cytoplasmic inclusion bodies in malignant immature myeloblasts or promyelocytes
- Myeloperoxidase (MPO) positive
Immunophenotype
- Immunohistochemistry
- ALL
- MPO negative
- Terminal deoxynucleotidyl transferase (TdT) positive
- TdT is a DNA polymerase involved in V(D)J recombination, which generates antigen receptor diversity during early lymphoid maturation.
- Periodic acid-Schiff (PAS): often positive
- AML
- MPO positive
- TdT negative
- PAS negative
- ALL
- Flow cytometry
Mnemonic
- 急性早幼粒(M3):CD13,CD33,CD117,CD9阳性。易并发DIC 过氧化物酶(MPO/POX)强阳性→急性早幼粒(M3)(郭三放羊——M3) “郭三放羊,姗姗(CD33)来迟,一生(CD13)有你(幼粒),差三分钟活到120”
- 急淋:PAS(糖原染色)阳性 “小淋吃糖” NSE(非特异性脂酶)、POX(髓过氧化物酶)阴性“带酶的都阴性”
- 急性粒细胞白血病:NSE阳性,不被氟化钠抑制(抑制<50%)“不离”
- 急性单核细胞白血病:NSE阳性,被氟化钠抑制(抑制≥50%)“被单”
Genetic studies
- APL: t(15;17) translocation, producing PML-RARA
Mnemonic
t(15; 17) = 571工程 早幼粒细胞 = 林立果造反
Differential diagnostics

Tip
Assessment of leukocyte alkaline phosphatase (an enzyme found in maturing neutrophils) can be used to distinguish marked leukocytosis due to leukemoid reaction from chronic myeloid leukemia (CML). Values are typically normal or increased in leukemoid reaction; in contrast, they are usually low in CML because the abnormal maturing neutrophils don’t bother to make these.
AML vs CML
| Feature | Acute Myeloid Leukemia (AML) | Chronic Myeloid Leukemia (CML) |
|---|---|---|
| Onset & Cells | Rapid; ≥20% Myeloblasts | Gradual; Mature & maturing granulocytes, <10% blasts (chronic phase) |
| Age (Typical) | Older adults (can occur at any age) | Middle-aged to older adults |
| Key Genetic | Various (e.g., t(15;17) in APL, FLT3) | Philadelphia Chromosome (t(9;22) → BCR-ABL) |
| Auer Rods | May be present | Absent |
| LAP Score | Variable (often normal/high) | Low |
| WBC Count | Variable (can be ↑, ↓, or normal) | Markedly ↑ (often >100,000) |
| Splenomegaly | Less common / less massive | Common, often massive |
| Symptoms | Acute: Pancytopenia symptoms (fatigue, bleeding, infection) | Chronic phase often asymptomatic or mild (fatigue, weight loss) |
| Basophilia | Not prominent | Often present |
| Treatment Focus | Induction Chemotherapy (e.g., 7+3); ATRA for APL | Tyrosine Kinase Inhibitors (TKIs) (e.g., Imatinib) |
| Progression | Aggressive from onset | Chronic → Accelerated → Blast Crisis (can resemble AML) |
- For WBC Count:
- AML: Rapid takeover by non-functional blasts, which can lead to variable peripheral counts as they either spill out or cause marrow failure.
- CML: Chronic overproduction of a whole spectrum of maturing (but abnormal) granulocytes, leading to consistently high counts.
- For Splenomegaly:
- AML: Acute disease course often doesn’t allow enough time for massive splenic infiltration before other critical symptoms arise from marrow failure.
- CML: Chronic proliferation leads to significant extramedullary hematopoiesis in the spleen over time, resulting in marked enlargement.
Treatment
Acute Lymphoblastic Leukemia (ALL)
- Standard Tx: Multi-drug chemotherapy regimens (e.g., vincristine, prednisone, asparaginase).
- Phases: Induction, Consolidation, Maintenance.
- CNS Prophylaxis: Mandatory; usually intrathecal methotrexate.
- Philadelphia Chromosome (+) ALL: Add a Tyrosine Kinase Inhibitor (TKI) like imatinib.
- Relapsed/Refractory: Immunotherapy (e.g., CAR T-cell therapy, blinatumomab).
Acute Myeloid Leukemia (AML)
- Standard Induction Tx: “7 + 3” regimen (cytarabine for 7 days + daunorubicin or idarubicin for 3 days).
- Consolidation: High-dose cytarabine or allogeneic HSCT.
- Acute Promyelocytic Leukemia (APL) subtype (t[15;17]):
- Tx: All-trans-retinoic acid (ATRA) + arsenic trioxide (ATO). This is curative and avoids standard chemo.
Chronic Myeloid Leukemia (CML)
- Pathophysiology: Caused by Philadelphia Chromosome (BCR-ABL fusion gene).
- First-Line Tx: Tyrosine Kinase Inhibitors (TKIs) that target BCR-ABL.
- Gold Standard: Imatinib.
- Others: Dasatinib, nilotinib.
- HSCT: Reserved for TKI failure or blast crisis.
Chronic Lymphocytic Leukemia (CLL)
- Early/Asymptomatic: Watch and wait (observation). No treatment needed.
- Symptomatic Disease Tx (Modern standard):
- Targeted Therapy (First-line):
- BTK inhibitors (e.g., ibrutinib, acalabrutinib).
- BCL-2 inhibitors (e.g., venetoclax), often with an anti-CD20 mAb (e.g., rituximab).
- Targeted Therapy (First-line):
- Chemoimmunotherapy: Older regimen (e.g., Fludarabine, Cyclophosphamide, Rituximab - FCR), now less common.
Tip
In APL, the t(15;17) translocation and subsequent formation of the PML-RARA fusion gene can inhibit myeloblast differentiation under physiological levels of retinoic acid. High doses of ATRA (a vitamin A derivative) may induce myeloblast differentiation and promote remission.